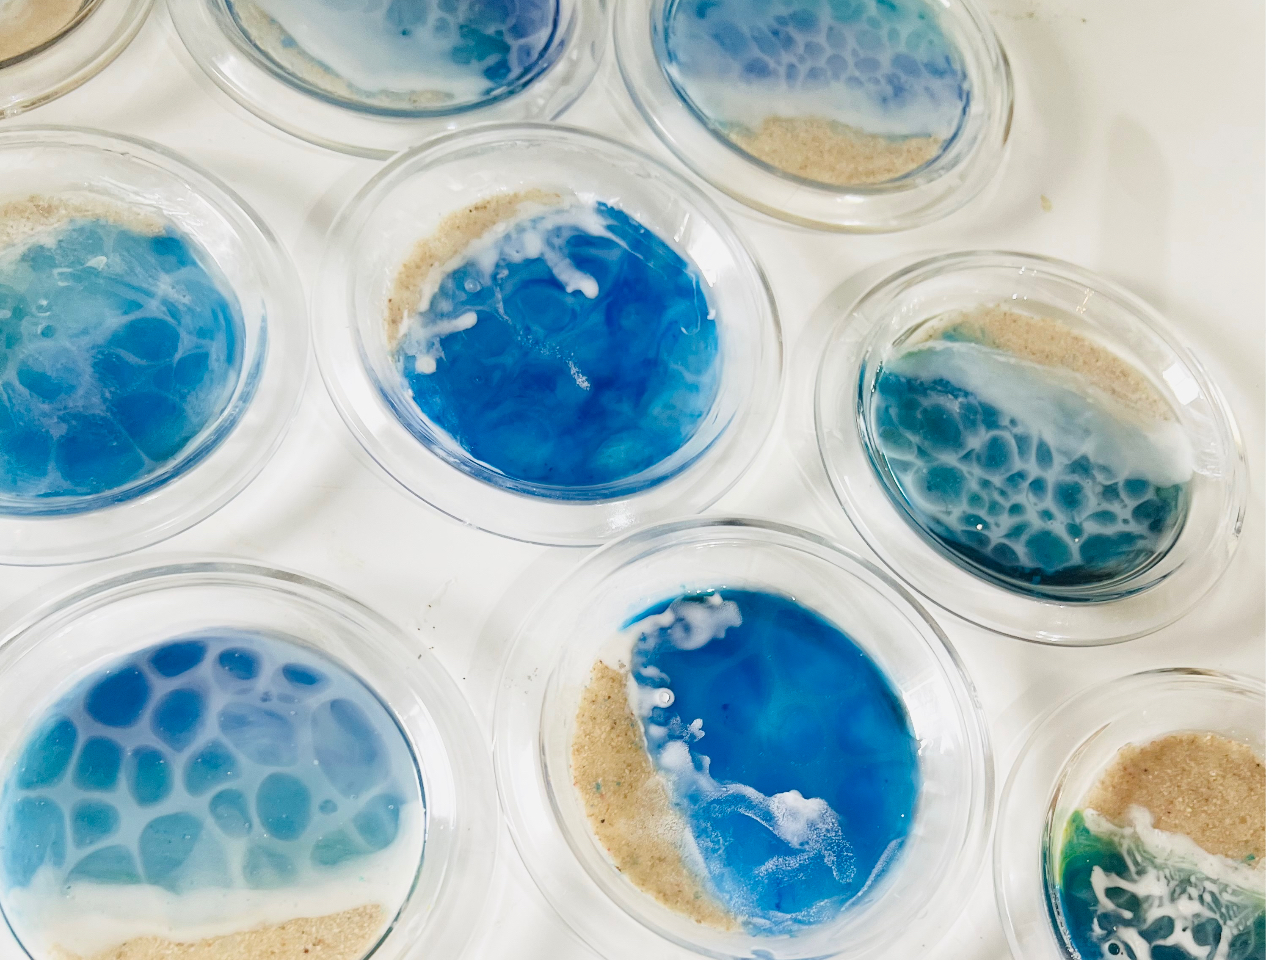
コースターの中に自分だけの海作り
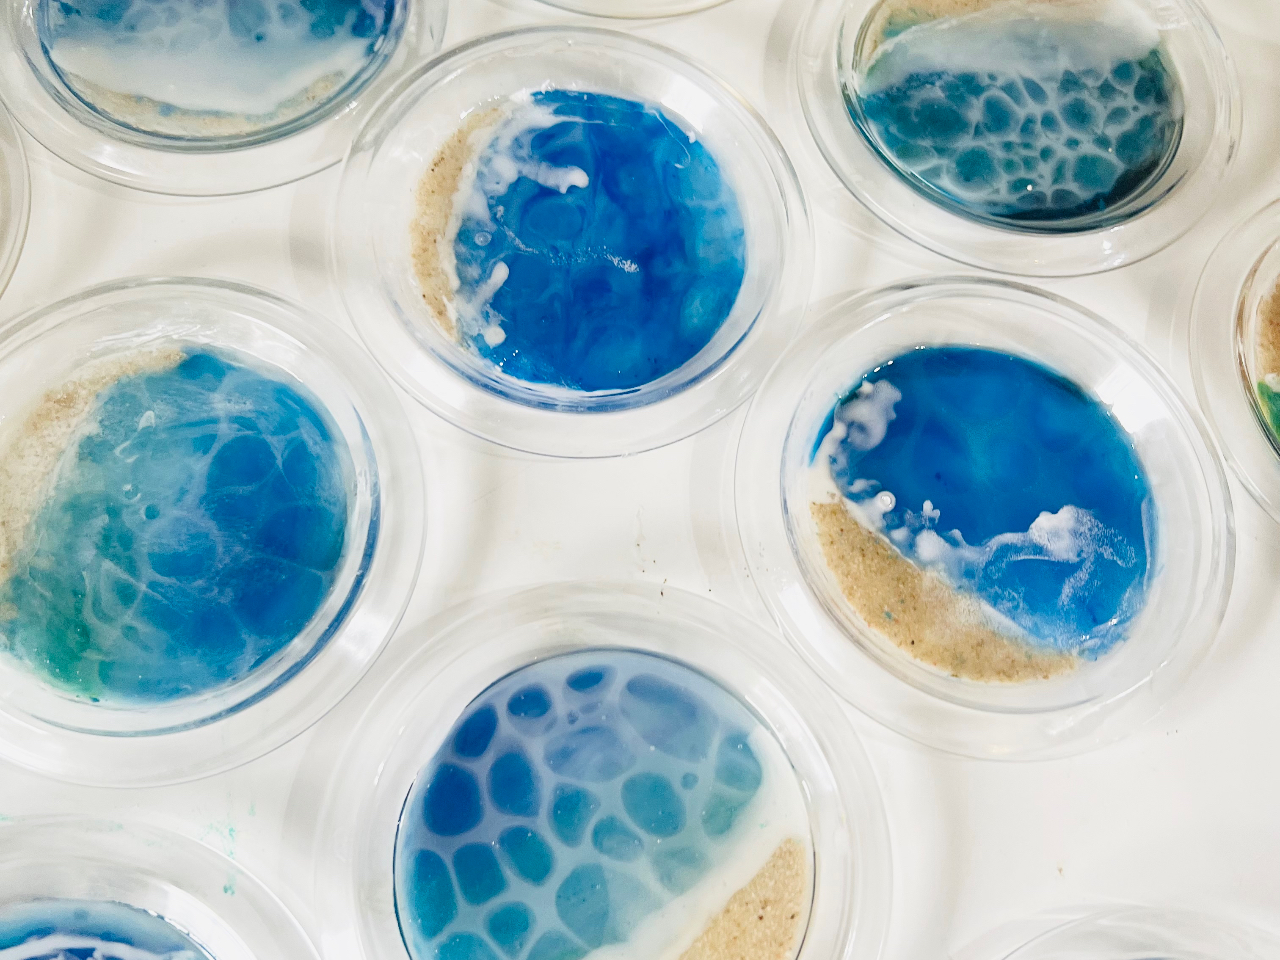

押花・レジンアトリエhana-ya
- エリア
-
-
東京
-
池袋・目白・板橋・赤羽
-
練馬区
-
貫井
-
- ジャンル
-
-
クラフト・工芸
-
その他クラフト・工芸
-
クラフト・工芸
-
押し花体験
-
クラフト・工芸
-
フラワーアレンジメント・ガーデニング
-
押花・レジンアトリエhana-yaのプラン一覧
全24件
※最新情報はプラン詳細画面にてご確認下さい。-

押し花スマホ・iPhoneケースレッスン
お花畑のようにかわいいスマホケースができあがります。初心者の方でもお楽しみいただけます押し花体験
東京都練馬区貫井3-12-1-223
大人
4,000円〜- 即時予約OK
- ポイント2%
- オンラインカード決済可
-

本物のお花でキャンドルを作ります。
飾っているだけでもかわいいお花のキャンドルが完成します!フラワーアレンジメント・ガーデニング
東京都練馬区貫井3−12−1ヴェールガーデン富士見台223号
大人
3,300円〜- 即時予約OK
- ポイント2%
-

押し花教室★自分だけの押し花標本をつくろう 3,300円 <じゃらん限定>
押し花のプロが教える「押し花教室」です★クラスの最後には、自分だけの押し花標本をつくれるようになっているはず★おでかけに、押し花標本を持ってでかけませんか?
フラワーアレンジメント・ガーデニング
東京都練馬区貫井3-12-1-223
大人
3,300円〜- 即時予約OK
- ポイント2%
- オンラインカード決済可
-

世界に一つだけのウエルカムボードがつくれる♪ブライダルレッスン 2時間 3,000円
大切な結婚式のブーケやウェルカムボード。ずーっと記念に飾りたいからこそ、ご自身でこだわって制作してみませんか?自分で作ると楽しいですよ!
フラワーアレンジメント・ガーデニング
東京都練馬区貫井3-12-1-223
大人
3,000円〜- ポイント2%
-

貴方だけの 可愛い押し花の箸置きを作りましょう。
レジンを使ってつくる、クリアなお洒落な押し花箸置きです押し花体験
東京都練馬区貫井3-12-1-223
大人
3,000円〜- 即時予約OK
- ポイント2%
-

ボールペンの中にお花がギュギュっと入った可愛いペンです。
フラワーアレンジメント・ガーデニング
東京都練馬区貫井3-12-1-223
大人
3,000円〜- 即時予約OK
- ポイント2%
-

赤ちゃんや、愛しいペットの足形を使って、可愛い押し花のアートフレームを作ります。
100%愛にあふれた、世界で一つのお花のフレームが完成します。
出産記念にもおすすめです!!押し花体験
東京都練馬区貫井3
大人
4,500円〜- 即時予約OK
- ポイント2%
- オンラインカード決済可
-

身近な自然の草花を使う魅力。ギフトにも喜ばれる押し花ウェルカムボード
押し花の風合いを存分に感じられる、ウェルカムボードをお作りいただけます。
フラワーアレンジメント・ガーデニング
東京都練馬区貫井3-12-1-223
大人
3,000円〜- ポイント2%
- オンラインカード決済専用
-

日本文化を味わう!筆ペンで簡単におしゃれ文字を描こう!己書体験
日本の文化筆文字を筆ペンで、簡単に体験してみませんか!自分の文字を活かしておしゃれな文字がかけるようになります。己書体験 はじめての方大歓迎!おひとり様OK♪/外国からの御旅行者様もどうぞ。
日本文化
東京都練馬区貫井3-12-1
大人
1,000円〜- ポイント2%
-

その日のうちにお持ち帰りいただけます。
憧れの海、思い出の海、自分の好きな海を作りましょうその他クラフト・工芸
東京都練馬区貫井3-12-1-223
大人
4,500円〜- 即時予約OK
- ポイント2%
-

その日のうちにお持ち帰りいただけます。
食卓におくとミニミニサイズの海がとても可愛いですよ
憧れの海、思い出の海、自分の好きな海を作りましょうその他クラフト・工芸
東京都練馬区貫井3-12-1-223
大人
3,500円〜- ポイント2%
-

その日のうちにお持ち帰りいただけます。
名刺交換で注目間違いなし!
名刺ケースのほかにカードケースとしてもご利用いただけます
憧れの海、思い出の海、自分の好きな海を作りましょうその他クラフト・工芸
東京都練馬区貫井3-12-1-223
大人
4,000円〜- ポイント2%
-

自分だけの海を作ろう オーシャンプレート 海レジンアート 波レジン
後日発想となります
インテリアとしてもぴったり
憧れの海、思い出の海、自分の好きな海を作りましょう
その他クラフト・工芸
東京都練馬区貫井3-12-1-223
大人
5,000円〜- ポイント2%
-

海シリーズ1日で沢山作る 自分だけの海を作ろう オーシャンプレート 波レジン
1日で、オーシャンプレート1枚、コースター2枚、はしおき2個、名詞ケース1個
すべてまとめて制作できます。
おたのしみの1日をお過ごしください
憧れの海、思い出の海、自分の好きな海を作りましょう
その他クラフト・工芸
東京都練馬区貫井3-12-1-223
大人
13,200円〜- ポイント2%
-

美しい押花額を仕上げて、色鮮やかに長く楽しむための密封をご体験いただけます。
押し花体験
東京都練馬区貫井3−12−1
大人
7,700円〜- 即時予約OK
- ポイント2%
-

-

ソラフラワー体験レッスン プルメリアのお花を作って夏にぴったりのスリッパを作ろう
1枚の植物のソラシートから
簡単にかわいいプルメリアを作って
スリッパに仕上げますフラワーアレンジメント・ガーデニング
東京都練馬区貫井3−12−1−223
大人
7,700円〜- 即時予約OK
- ポイント2%
-

お花の配置から
紙の質感まで
自分らしい「トキメク一冊」を
丁寧に仕上げます
人気の御朱印帳 好きな押し花で可愛い御朱印帳を作ろう
外国からの観光の方にもおすすめ押し花体験
東京都練馬区貫井3−12−1−223
大人
5,000円〜- 即時予約OK
- ポイント2%
-

本物の植物で作る 自分だけのクマちゃん
出産や結婚、プロポーズの記念などにもピッタリです
変色しない密封方法も学びます押し花体験
東京都練馬区貫井3−12−1−223
大人
10,000円〜- 即時予約OK
- ポイント2%
-

ソラフラワー体験レッスン 夏にピッタリひまわりのお花を作ってブーケに仕上げよう!
1枚の植物のソラシートから
簡単にかわいいひまわりを作って
まあるい可愛いブーケに仕上げますフラワーアレンジメント・ガーデニング
東京都練馬区貫井3−12−1−223
大人
7,700円〜- 即時予約OK
- ポイント2%
-

1枚ソラシートで作ったお花を組み替えて
素敵なおしゃれコサージュに仕上げます
軽くてとっても使いやすいですフラワーアレンジメント・ガーデニング
東京都練馬区貫井3−12−1−223
大人
7,700円〜- 即時予約OK
- ポイント2%
-

その日のうちにお持ち帰りいただけます。
憧れの海、思い出の海、自分の好きな海をドレスチャームにして仕上げましょうその他クラフト・工芸
東京都練馬区貫井3-12-1-223
大人
4,000円〜- 即時予約OK
- ポイント2%
-

ソラフラワー体験レッスン ダリアのお花を作って美しいスワッグを作ろう
1枚の植物のソラシートから
簡単にかわいいダリアを作って
スリッパに仕上げますフラワーアレンジメント・ガーデニング
東京都練馬区貫井3−12−1−223
大人
7,700円〜- 即時予約OK
- ポイント2%
-

日本の文化筆文字を筆ペンで、簡単に体験で大切な名前を描きます。己書体験 はじめての方大歓迎!おひとり様OK♪/外国からの御旅行者様もどうぞ。
日本文化
東京都練馬区貫井3-12-1
大人
3,000円〜- ポイント2%